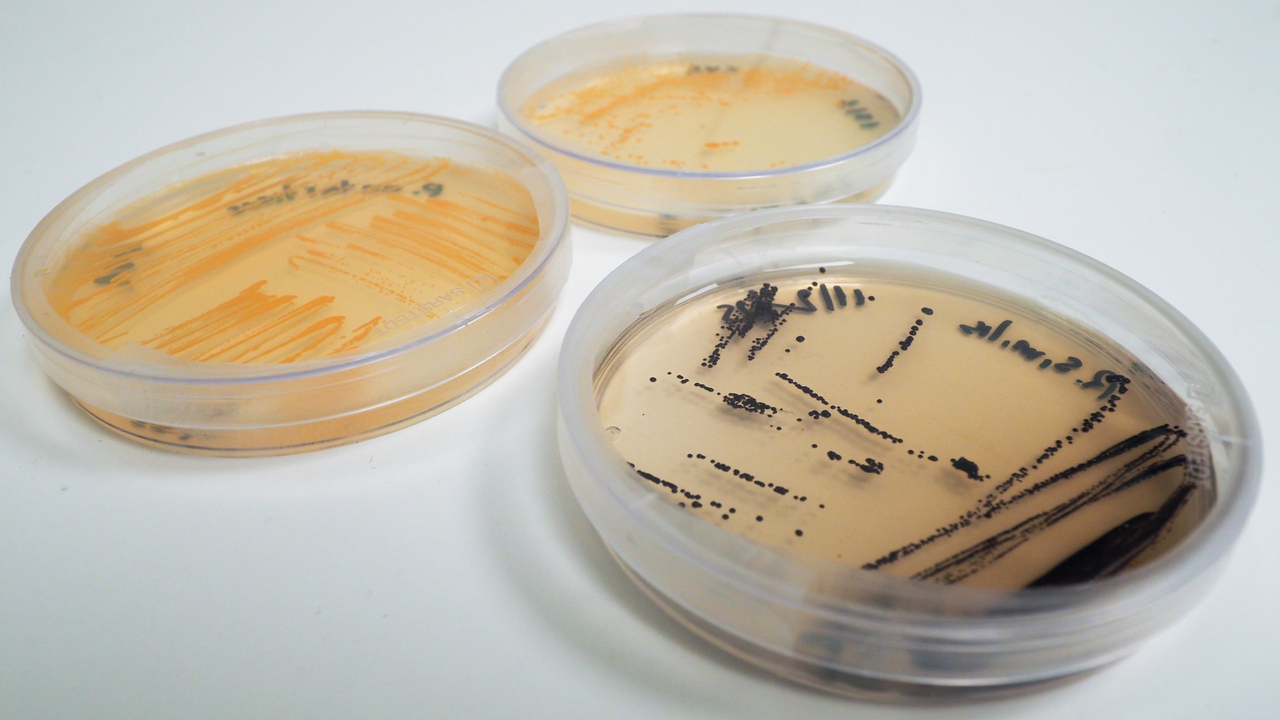
Petriskålar

Interdisciplinärt samarbete
Alef dos Santos forskning är del av ett tvärvetenskapligt projekt som samlar forskare vid flera av insitutionerna inom Kemiskt-Biologiskt Centrum, KBC. Hans forskning möjliggörs tack vare samarbete med forskare från Kemiska institutionen, Institutionen för ekologi, miljö och geovetenskap och Umeå marina forskningscentrum.
Projektet är finansierat av Kempestiftelserna.